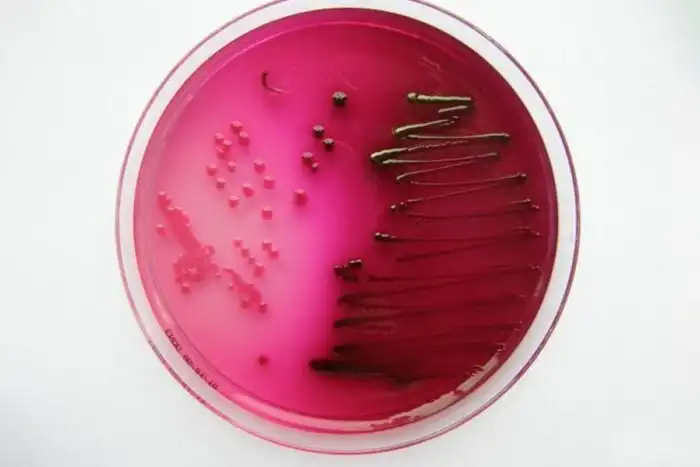

Микробы, бактерии, вирусы – миллионы, миллиарды существ, обитающие вокруг и внутри нас. Одни из них признаются условно полезными для человека, другие приводят к болезням.
Но какая между ними разница? В чем отличие между бактерией и вирусом, а главное, кто из них опаснее?
Мир микроорганизмов
Микробы – собирательное название живых существ, которые настолько малы, что их невозможно увидеть невооруженным взглядом.
В этом царстве обитают археи, грибы, протисты, вирусы и бактерии. Это первые существа, появившиеся на планете в процессе эволюции. Именно они являются настоящими хозяевами мира, обитают практически в любой среде и обладают невероятной способностью к выживанию.
Посчитано, что только масса бактерий в 1166 раз больше массы всего человечества вместе взятого. Их число достигает 5 нониллионов (цифры с 30-ю нулями). В грамме почвы в среднем обитает 40 миллионов таких существ. Вирусы и вовсе не поддаются подсчету.
На одном квадратном метре грунта может располагаться до нескольких миллиардов вирусов и сотни миллионов бактерий.
Самыми грязными предметами, изобилующими организмами из невидимого мира, признаются домашние ковры, губки для мытья посуды, компьютерные клавиатуры, мойки, столы и мобильные телефоны.
Что отличает бактерий от других микробов?
Большинство организмов в мире состоят из клеток. Это своеобразные кирпичики, из которых строится ткань. Каждый такой кирпичик имеет ядро. Оно необходимо для хранения генетического материала, контролирует рост и размножение клетки.
Бактерии кишечной палочки
Бактерия состоит всего из одной клетки, которая, помимо всего прочего, не имеет ядра. У такого микроорганизма иной способ размножения и передачи ДНК. Такие существа получили название прокариоты.
Похожими на бактерии являются археи. До 1990 года их не выделяли в отдельную группу. Однако позже выяснилось, что эволюция у архей и бактерий продвигалась разными путями и генетически археи ближе к эукариотам.
Считается, большая часть бактерий безвредна, а их рост сдерживается иммунитетом человека. Некоторые из них даже приносят пользу – предотвращают появление инфекций, помогают усваивать пищу в кишечнике и т.д.
Тем не менее, часть бактерий находится по ту сторону закона. Чума, холера, сибирская язва – вот далеко не полный перечень заболеваний, которые вызывают эти маленькие убийцы.
В целом, в человеческом организме нашли приют около 39 триллионов бактерий. Их общий вес достигает двух килограммов!
Кто такой вирус?
У вируса вообще нет клеточной структуры. Это его главная отличительная черта.
В мире микробов вирусы отъявленные разбойники, которые захватывают чужие клетки и насильно заставляют их воспроизводить себе подобных существ.
Вирус в тысячу раз меньше бактерии. Поэтому он может атаковать даже других микробов.
Правда, среди вирусов тоже есть хорошие ребята – бактериофаги. Таких "хищников", в ряде случаев, используют вместо антибиотиков для лечения бактериальных инфекций. Бактериофаги находят в организме микроба, вызывающего патологию и, "убивают" его.
Что опаснее, вирус или бактерия?
Считается, что вирус опасней. В отличие от бактерий, данный микроорганизм способен к генетическим мутациям.
Вирус герпеса, окружённый липидной оболочкой (суперкапсидом)
Год от года вирусы становятся злее, приобретают устойчивость к лекарствам и расширяют список организмов, на которых они нападают. Так, например, болезни, которые раньше были свойственны лишь животным, начинают передаваться людям.
Кроме того, вирусы крайне сложно полностью вывести из клеток. Паразиты могут "прописаться" внутри нашего организма вызывая хронические заболевания всю жизнь.